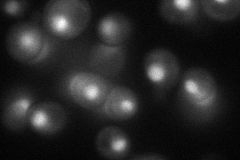
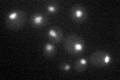

View description
Component of the Rpd3p/Sin3p deacetylase complex required for its structural integrity and catalytic activity, involved in transcriptional silencing and required for sporulation; cells defective in SDS3 display pleiotropic phenotypes
Localization:
Intensity:
Fold change:
Significance:
-
C’ GFP library in SD

nucleus29.91 -
N' NOP1pr-GFP in SD
nucleus59.0698 -
N' TEF2pr-mCherry in SD

nucleus22.0248 -
N' NATIVEpr-GFP in SD

nucleus26.7337 -
N' TEF2pr-VC and Cyto-VN in SD

below threshold26.9161 -
C’ GFP library in SD+DTT

nucleus30.671.02No -
C’ GFP library in SD+H2O2

nucleus31.971.06No -
C’ GFP library in Starvation Media
nucleus30.941.03No -
C’ GFP library on the background of Pup2-DaMP

nucleus -
C’ GFP library on the background of CCT mutant

nucleus33.42541.11709No
